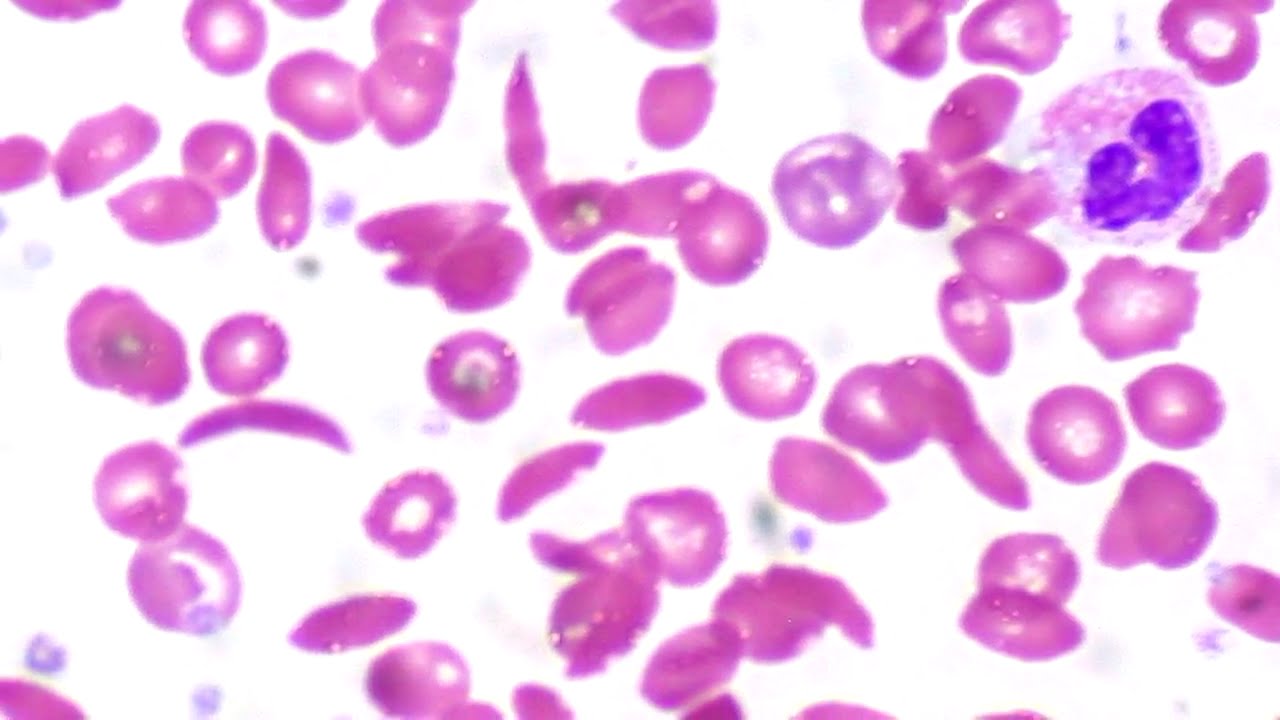
Серповидно-клеточная анемия – не доказательство эволюции

Серповидноклеточная анемия — наследственное заболевание, влияющее на форму и функциональность красных кровяных клеток, что может вызвать серьезные осложнения и ухудшение качества жизни. В статье рассмотрим причины заболевания, характерные симптомы и проявления в разных возрастных группах, а также гемолитические кризы, методы диагностики и современные подходы к лечению. Понимание этих аспектов поможет пациентам и их близким ориентироваться в проблеме, обращаться за медицинской помощью и принимать обоснованные решения о лечении.
Причины появления
Название заболевания возникло из-за характерной формы кровяных клеток, которые начинают напоминать серпы. Это происходит из-за аномального строения гемоглобина. Такие изменения легко заметить под микроскопом. В норме эритроциты имеют округлую и двояковогнутую форму.
Среди пациентов выделяют два основных типа. Первый тип — гомозиготные носители, у которых в эритроцитах содержится только гемоглобин S. Это заболевание передается по обеим линиям наследования. Симптомы у таких пациентов выражены значительно, а лечение оказывается менее эффективным. Второй тип — гетерозиготы, у которых в крови присутствует равное количество нормального и аномального гемоглобина. Наследование происходит только по одной линии. Симптоматика практически отсутствует и может проявляться лишь в экстремальных условиях, таких как сильное обезвоживание или пребывание на высоких высотах.
В норме в крови человека содержится только гемоглобин A. При патологических изменениях он способен переносить меньше кислорода, а эритроциты имеют короткий срок жизни. Они становятся нестабильными и легко разрушаются под действием различных ферментов. Из-за утраты нормальной эластичности клетки начинают склеиваться, что приводит к сужению сосудов и образованию тромбов. В результате ткани и органы испытывают гипоксию.
Серповидноклеточная анемия наиболее распространена в регионах с высоким уровнем заболеваемости малярией. Люди, страдающие от этой анемии, обладают невосприимчивостью к возбудителю инфекции.

Серповидноклеточная анемия является наследственным заболеванием, которое вызывает деформацию красных кровяных клеток, что приводит к различным осложнениям. Врачи отмечают, что основные симптомы включают хроническую усталость, боли в животе и суставах, а также частые инфекции. Эти проявления обусловлены нарушением кровообращения и недостатком кислорода в тканях. Лечение заболевания требует комплексного подхода. Врачи рекомендуют регулярный мониторинг состояния пациента, использование обезболивающих средств при кризах и, в некоторых случаях, переливание крови. Современные методы терапии, такие как генной терапии и препараты, способствующие образованию нормальных эритроцитов, открывают новые горизонты в лечении. Важно, чтобы пациенты находились под наблюдением специалистов, что позволяет своевременно корректировать терапию и улучшать качество жизни.
Характерные симптомы
Признаки заболевания начинают проявляться уже в первые месяцы жизни. Врачи выделяют несколько этапов развития патологии. Первый из них охватывает период с рождения до трех лет. На этом этапе ребенок выглядит вполне здоровым, однако у него начинают наблюдаться отеки кистей и стоп. Это связано с тем, что эритроциты выпадают из плазмы крови и накапливаются в мелких капиллярах, образуя осадок, что вызывает сильную боль у малыша.
С течением времени появляются и другие признаки серповидноклеточной анемии:
- бледность или желтоватый оттенок кожи;
- боли в животе, спине и конечностях;
- возможное повышение температуры.
Иногда у детей может произойти закупорка сосудов селезёнки. Этот орган отвечает за фильтрацию крови, и его функциональные нарушения могут привести к сепсису. Поэтому при возникновении раздражительности и повышении температуры необходимо незамедлительно обратиться к врачу.
С трех до десяти лет наблюдается закупорка капилляров в костях. Проблемы могут возникать и в других органах, что проявляется ноющей болью в определенных участках тела.
С десяти лет у детей отмечается повышенная нервозность, а задержка физического и психического развития становится более заметной. Половое созревание может задерживаться, однако это не сказывается на детородной функции в будущем.
У женщин наблюдаются нарушения репродуктивной функции. Менструации начинаются поздно, цикл становится нерегулярным, а во время беременности возможны самопроизвольные аборты.
У взрослых серповидная анемия приобретает хронический характер. Закупорка капилляров может происходить в различных органах, таких как почки, сетчатка глаз, легкие, головной мозг и другие. Это приводит к постоянной усталости, головокружениям и иногда к желтухе.
Важно отметить, что у каждого пациента симптомы могут проявляться по-разному.

| Категория | Симптомы | Лечение |
|---|---|---|
| Общие симптомы | Хроническая усталость, бледность кожи, одышка, задержка роста и развития у детей, повышенная восприимчивость к инфекциям. | Поддерживающая терапия: фолиевая кислота, обезболивающие, переливания крови (при необходимости). |
| Кризы (осложнения) | Вазоокклюзионные кризы: сильная боль в костях, суставах, груди, животе; Острый грудной синдром: боль в груди, кашель, лихорадка, одышка; Секвестрация селезенки: резкое увеличение селезенки, падение гемоглобина; Апластический криз: резкое снижение выработки эритроцитов. | Вазоокклюзионные кризы: обезболивающие (опиоиды), гидратация, кислородная терапия. Острый грудной синдром: антибиотики, кислород, переливания крови. Секвестрация селезенки: экстренное переливание крови, спленэктомия (удаление селезенки). Апластический криз: переливания крови. |
| Долгосрочные осложнения | Повреждение органов (почки, печень, легкие, сердце), инсульты, язвы на ногах, приапизм (длительная болезненная эрекция), холелитиаз (камни в желчном пузыре), ретинопатия (повреждение сетчатки глаза). | Гидроксимочевина: снижает частоту кризов и улучшает качество жизни. Трансплантация костного мозга: единственный метод радикального лечения, но сопряжен с рисками. Генная терапия: перспективное, но пока экспериментальное направление. |
| Профилактика | Вакцинация (против пневмококка, гриппа), регулярные медицинские осмотры, избегание обезвоживания и переохлаждения, прием фолиевой кислоты. |
Гемолитические кризы
При серповидноклеточной анемии часто возникают приступы, во время которых уровень гемоглобина может упасть до критически низких значений, температура тела повышается, а моча приобретает темный цвет. Существует три основных типа кризов:
- Апластический — характеризуется угнетением образования эритроцитов в костном мозге и резким снижением уровня гемоглобина. В этом случае организм активно использует фолиевую кислоту.
- Секвестрационный — возникает из-за накопления крови в печени и селезенке, что приводит к их увеличению. При этом наблюдается артериальная гипотония.
- Сосудисто-окклюзионные — возникают в результате различных тромбозов, затрагивающих почки, миокард и другие органы.
Приступ может длиться до месяца, за это время в организме пациента происходят значительные изменения: наблюдается болезненная худоба, искривление позвоночника и зубов, удлинение туловища. Резкое увеличение печени может привести к таким серьезным заболеваниям, как цирроз, диабет и желчнокаменная болезнь. При закупорке сосудов в ногах развиваются трофические язвы, которые сложно поддаются лечению. Также при нарушениях мозгового кровообращения могут возникать параличи и парезы.
Если пациент переживает криз, его ожидает множество осложнений. Врачи будут заниматься лечением повреждений внутренних органов различной степени тяжести.
https://youtube.com/watch?v=KgIVjsJnEYk
Способы диагностики
Заболевание выявляется сразу после рождения. Если один из родителей имеет данное заболевание, биопсию могут провести еще во время беременности. Для подтверждения диагноза выполняется анализ крови, который покажет характерные изменения:
- значительно сниженный уровень гемоглобина;
- повышенное количество лейкоцитов;
- наличие ретикулоцитов;
- уровень билирубина выше нормы.
При микроскопическом исследовании специалист сможет увидеть эритроциты в форме серпа. Также будут обнаружены тельца Жолли и кольца Кабо. С помощью электрофореза определяется содержание гемоглобина в эритроците и устанавливается, является ли пациент гомозиготой или гетерозиготой. В некоторых случаях может потребоваться пункция костного мозга.
Важно провести дифференциальную диагностику, чтобы исключить такие заболевания, как вирусный гепатит А, костный туберкулез, рахит, ревматоидный артрит и другие.
https://youtube.com/watch?v=3jSknhVI3Ns
Варианты лечения
Серповидноклеточная анемия является хроническим заболеванием, которое не поддается полному излечению. Пациентам необходимо постоянное наблюдение у специалиста-гематолога на протяжении всей жизни. Основные усилия как врача, так и пациента сосредоточены на предотвращении кризисных состояний. В случае обострения заболевания требуется госпитализация, где проводится комплексное лечение.
Терапия включает в себя применение антибиотиков, обезболивающих средств, дезагрегантов и антикоагулянтов, а также фолиевой кислоты и дополнительного введения жидкости. Для борьбы с гипоксией назначается кислородная терапия. Остальные мероприятия направлены на устранение возникших осложнений.
Важно организовать дробное питание. Голодание может привести к кризам, поэтому рекомендуется есть 5−6 раз в день небольшими порциями. Следует внимательно контролировать объем потребляемой жидкости. Необходимо исключить из рациона жирные, соленые и копченые продукты, сладости и выпечку. В некоторых случаях могут быть назначены желчегонные средства.
Постгеморрагическая анемия: виды заболевания и методы леченияПостгеморрагическая анемия – это патологическое состояние, возникающее после утраты крови организмом. Это не является…
Физические нагрузки должны быть строго ограничены, рекомендуется избегать экстремальных видов спорта, таких как альпинизм или горные походы. Лучше всего ограничиться легкой зарядкой.
Для борьбы с гипоксией может применяться гипербарическая оксигенация. Эта процедура способствует насыщению организма кислородом и способствует заживлению трофических язв.

Прогноз болезни
Полностью исключить риск возникновения болезни у ребенка невозможно. Если один из родителей имеет заболевание, рекомендуется обратиться к генетику. Этот специалист поможет оценить все возможные риски, связанные с рождением ребенка. При желании женщина может рассмотреть вариант прерывания беременности по медицинским показаниям.
Люди с данным заболеванием редко доживают до 48 лет. Большинство из них умирает в раннем детстве, в основном из-за осложнений, таких как инфекции или тромбозы. Для поддержания здоровья важно вести активный образ жизни и максимально избегать факторов, способствующих ухудшению состояния. Все заболевания требуют своевременного медицинского вмешательства.
Рекомендуется пройти вакцинацию против пневмококковой и менингококковой инфекций. Не стоит пытаться лечить серповидноклеточную анемию с помощью народных средств или альтернативных методов, так как это не принесет пользы и может увеличить риск кризов.
Следуя рекомендациям врачей, можно значительно продлить жизнь и улучшить ее качество. Возможно, в будущем появится экспериментальное лечение, способное избавить пациентов от этого заболевания крови.
Профилактика осложнений
Профилактика осложнений при серповидноклеточной анемии является важной частью комплексного подхода к лечению и поддержанию здоровья пациентов. Серповидноклеточная анемия — это наследственное заболевание, при котором происходит аномальное формирование гемоглобина, что приводит к изменению формы эритроцитов. Эти деформированные клетки могут вызывать различные осложнения, поэтому профилактика играет ключевую роль в управлении состоянием пациента.
Одним из основных направлений профилактики осложнений является регулярное медицинское наблюдение. Пациенты с серповидноклеточной анемией должны проходить плановые осмотры у гематолога, который сможет отслеживать изменения в состоянии здоровья и при необходимости корректировать лечение. Важно также проводить регулярные анализы крови для оценки уровня гемоглобина и выявления возможных признаков анемии.
Еще одним важным аспектом является вакцинация. Пациенты с серповидноклеточной анемией подвержены повышенному риску инфекционных заболеваний, поэтому вакцинация против пневмококка, менингококка и гриппа является обязательной. Это поможет снизить вероятность инфекционных осложнений, которые могут усугубить состояние пациента.
Обеспечение адекватного гидратационного режима также играет важную роль в профилактике осложнений. Пациенты должны пить достаточное количество жидкости, чтобы предотвратить сгущение крови и образование тромбов. Особенно это актуально в жаркую погоду или при физических нагрузках.
Избегание триггеров, способствующих кризам, также является важной частью профилактики. К таким триггерам относятся высокие altitudes, чрезмерные физические нагрузки, стресс и инфекции. Пациенты должны быть осведомлены о своих триггерах и стараться избегать ситуаций, которые могут привести к кризам.
Кроме того, важно следить за состоянием органов и систем, наиболее подверженных осложнениям, таких как легкие, почки и печень. Регулярные обследования помогут выявить возможные проблемы на ранних стадиях и начать своевременное лечение.
Наконец, поддержка со стороны семьи и сообщества также играет важную роль в профилактике осложнений. Психологическая поддержка, участие в группах самопомощи и образовательные программы могут помочь пациентам справляться с эмоциональными и социальными аспектами заболевания, что в свою очередь способствует улучшению общего состояния здоровья.
Психосоциальные аспекты жизни с анемией
Серповидноклеточная анемия не только влияет на физическое здоровье человека, но и имеет значительное воздействие на его психосоциальное состояние. Люди, страдающие от этого заболевания, часто сталкиваются с различными эмоциональными и социальными трудностями, которые могут усугублять их общее состояние и качество жизни.
Одним из основных психосоциальных аспектов является чувство изоляции. Пациенты с серповидноклеточной анемией могут испытывать трудности в социальной адаптации, особенно в детском и подростковом возрасте. Ограничения, связанные с физическим состоянием, могут приводить к пропуску занятий в школе или отказу от участия в спортивных мероприятиях, что, в свою очередь, может вызывать чувство одиночества и неполноценности.
Кроме того, хроническая боль и усталость, характерные для этого заболевания, могут вызывать депрессию и тревожные расстройства. Пациенты часто испытывают страх перед возможными осложнениями, такими как острые боли в животе или легких, что может приводить к постоянному стрессу и беспокойству. Эти эмоциональные состояния могут негативно сказываться на их способности справляться с повседневными задачами и поддерживать здоровые отношения с окружающими.
Семейная динамика также может изменяться из-за наличия серповидноклеточной анемии. Члены семьи могут испытывать стресс из-за необходимости заботиться о больном, что может привести к конфликтам и напряженности в отношениях. Важно, чтобы семьи получали поддержку и информацию о заболевании, чтобы лучше понимать, как помочь своим близким и справляться с возникающими трудностями.
Социальная поддержка играет ключевую роль в жизни людей с серповидноклеточной анемией. Группы поддержки и консультации могут помочь пациентам и их семьям справляться с эмоциональными и социальными проблемами. Общение с другими людьми, которые сталкиваются с аналогичными трудностями, может значительно улучшить психоэмоциональное состояние и повысить качество жизни.
Важно также отметить, что психосоциальные аспекты жизни с серповидноклеточной анемией требуют комплексного подхода к лечению. Включение психологической помощи и поддержки в общий план лечения может значительно улучшить состояние пациентов и помочь им адаптироваться к жизни с этим заболеванием. Психотерапия, консультирование и участие в группах поддержки могут стать важными компонентами в управлении как физическими, так и эмоциональными аспектами болезни.
Современные исследования и перспективы лечения
Современные исследования в области серповидноклеточной анемии (СА) направлены на улучшение понимания патогенеза заболевания, а также на разработку новых методов лечения и профилактики. Одним из ключевых направлений является изучение генетических механизмов, лежащих в основе заболевания. В последние годы активно развиваются технологии редактирования генов, такие как CRISPR/Cas9, которые открывают новые горизонты для потенциального лечения СА путем коррекции мутации в гене HBB, отвечающем за синтез бета-глобина.
Кроме того, исследуются новые препараты, направленные на увеличение уровня гемоглобина F (фетального гемоглобина), который не подвержен серповидной деформации. Одним из таких препаратов является гидроксимочевина, который уже используется в клинической практике для снижения частоты кризов и улучшения общего состояния пациентов. Однако, несмотря на положительные результаты, необходимы дополнительные исследования для определения долгосрочной эффективности и безопасности этого лечения.
В последние годы также наблюдается рост интереса к клеточной терапии, включая трансплантацию стволовых клеток. Эта методика может предложить потенциальное излечение для некоторых пациентов, особенно для детей с тяжелой формой заболевания, однако она сопряжена с высокими рисками и требует тщательного подбора доноров.
Исследования в области иммунотерапии также показывают многообещающие результаты. Ученые работают над созданием вакцин и антител, которые могут помочь организму справляться с осложнениями, связанными с серповидноклеточной анемией, такими как инфекции и острые боли. Эти подходы могут значительно улучшить качество жизни пациентов и снизить частоту госпитализаций.
Важным аспектом современных исследований является также изучение влияния образа жизни и диеты на течение заболевания. Установлено, что регулярные физические нагрузки, сбалансированное питание и адекватная гидратация могут способствовать улучшению состояния пациентов с СА. В связи с этим разрабатываются рекомендации по образу жизни, которые могут помочь в управлении симптомами и профилактике осложнений.
Таким образом, современные исследования в области серповидноклеточной анемии открывают новые перспективы для лечения и улучшения качества жизни пациентов. Однако для достижения значительных успехов необходимо продолжать научные изыскания, клинические испытания и внедрение новых технологий в практическую медицину.














